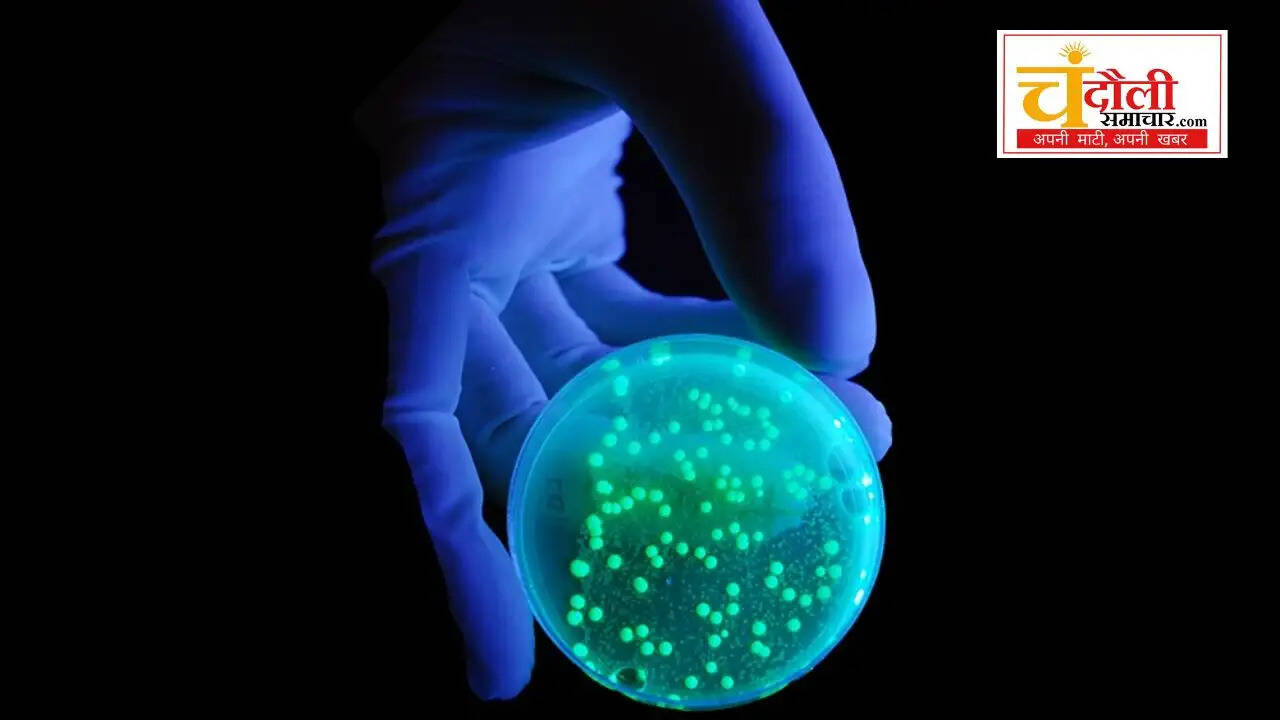
science of ultraviolet rays explain, chandauli news space updates,

अदृश्य किरणों का रहस्य: क्या है अल्ट्रावॉयलेट लाइट और यह कैसे बदलती है ब्रह्मांड की समझ?
अल्ट्रावॉयलेट (यूवी) किरणें सूरज से निकलने वाली वे अदृश्य ऊर्जा तरंगें हैं, जो जीवन और विज्ञान दोनों के लिए महत्वपूर्ण हैं। जानिए इनके प्रकार, जोहान रिटर की ऐतिहासिक खोज और नासा द्वारा अंतरिक्ष में इनका उपयोग।
अदृश्य पराबैंगनी किरणों का वैज्ञानिक आधार
यूवी-ए, यूवी-बी और यूवी-सी में अंतर
जोहान रिटर की साल 1801 की महान खोज
ओजोन परत द्वारा यूवी किरणों का बचाव
नासा के उपग्रहों द्वारा तारों का अध्ययन
ब्रह्मांड कई तरह की ऊर्जा तरंगों से भरा हुआ है, जिनमें से कुछ हमें दिखाई देती हैं और कुछ अदृश्य रहती हैं। इन्ही अदृश्य तरंगों में से एक है अल्ट्रावॉयलेट (यूवी) लाइट, जिसे हिंदी में पराबैंगनी किरणें कहा जाता है। यह एक विशिष्ट विद्युत चुंबकीय तरंग है, जिसकी तरंगदैर्ध्य (वेवलेंथ) दृश्य प्रकाश से कम होती है। यद्यपि मानवीय आंखें इन्हें नहीं देख सकतीं, लेकिन मधुमक्खियों जैसे कुछ जीवों में इन्हें देखने की प्राकृतिक क्षमता होती है।

सूरज: यूवी किरणों का सबसे बड़ा स्रोत
सूरज हमारे सौर मंडल में यूवी लाइट का मुख्य स्रोत है। वैज्ञानिकों ने सूरज से आने वाली इन किरणों को उनकी तीव्रता और प्रभाव के आधार पर तीन श्रेणियों में बांटा है:
यूवी-ए (UV-A): इनकी तरंग सबसे लंबी होती है। ये त्वचा की गहराई तक पहुंचती हैं और समय से पहले बुढ़ापा आने का कारण बनती हैं।
यूवी-बी (UV-B): ये किरणें सनबर्न और डीएनए क्षति के लिए जिम्मेदार होती हैं। शुक्र है कि हमारी पृथ्वी की ओजोन परत लगभग 95% यूवी-बी किरणों को सोख लेती है।
यूवी-सी (UV-C): ये सबसे अधिक ऊर्जावान और खतरनाक होती हैं, लेकिन वायुमंडल इन्हें पृथ्वी की सतह तक पहुंचने से पहले ही पूरी तरह रोक लेता है।
इतिहास: जोहान रिटर की वह ऐतिहासिक खोज
यूवी लाइट की खोज का श्रेय जर्मन वैज्ञानिक जोहान रिटर को जाता है, जिन्होंने साल 1801 में एक प्रयोग किया था। उन्होंने देखा कि फोटोग्राफिक पेपर नीली रोशनी के मुकाबले बैंगनी रंग से परे मौजूद अदृश्य क्षेत्र में रखने पर ज्यादा तेजी से काला हो गया। इसी प्रयोग से यह सिद्ध हुआ कि बैंगनी रंग के आगे भी ऊर्जा मौजूद है, जिसे बाद में 'अल्ट्रावॉयलेट' नाम दिया गया।
अंतरिक्ष विज्ञान में यूवी लाइट का महत्व
एस्ट्रोनॉमर यूवी लाइट को और भी सूक्ष्म श्रेणियों में विभाजित करते हैं, जैसे नियर यूवी (NUV), मिडिल यूवी (MUV), फार यूवी (FUV) और एक्सट्रीम यूवी (EUV)। अमेरिकी स्पेस एजेंसी नासा (NASA) के सोलर डायनेमिक्स ऑब्जर्वेटरी (SDO) ने सूरज की 'एक्सट्रीम यूवी' तस्वीरें ली हैं। इन तस्वीरों में अलग-अलग रंग सूरज के प्लाज्मा के तापमान को दर्शाते हैं। उदाहरण के लिए, नीला और हरा रंग उन क्षेत्रों को दिखाता है जहाँ तापमान दस लाख डिग्री सेल्सियस से भी अधिक होता है।
तारों के जन्म और गैलेक्सी का अध्ययन
यूवी लाइट वैज्ञानिकों के लिए ब्रह्मांड का नक्शा समझने का एक बेहतरीन औजार है। नए बने तारे यूवी लाइट में सबसे अधिक चमकते हैं। नासा के 'गैलेक्स मिशन' ने एम81 गैलेक्सी की ऐसी तस्वीरें ली हैं, जिनमें नए तारों के बनने वाले क्षेत्र स्पष्ट रूप से दिखाई देते हैं। दृश्य प्रकाश (Visible Light) में जहां हमें पुराने और ठंडे तारे दिखते हैं, वहीं यूवी लाइट की मदद से हम नए, भारी और गर्म तारों का अध्ययन कर सकते हैं। इससे गैलेक्सी के विकास और तारों की जीवन यात्रा को समझने में मदद मिलती है।
Tags
चंदौली जिले की खबरों को सबसे पहले पढ़ने और जानने के लिए चंदौली समाचार के टेलीग्राम से जुड़े।*







